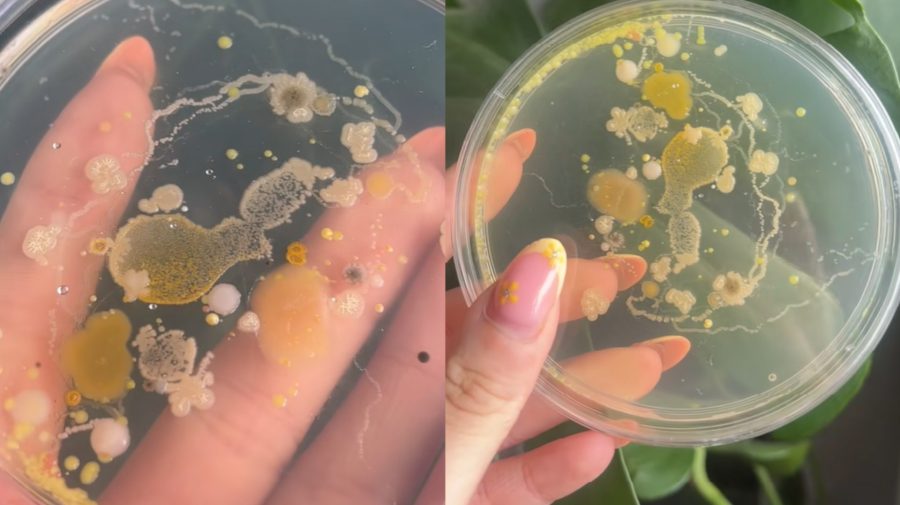

Tiktokerka zistila, kde má naše telo najviac baktérií. Výsledok ľudí zhnusil (VYJADRENIE VEDCOV)
- Nadaná dizajnérka použila Petriho misku
- Výsledok sa môže javiť ako odporný, ale je logický, tvrdia vedci
- Nadaná dizajnérka použila Petriho misku
- Výsledok sa môže javiť ako odporný, ale je logický, tvrdia vedci
Chloe Fitzpatricková, ktorá býva v škótskom Aberdeenshire, nedávno vykonala zaujímavý experiment na odhalenie oblasti tela s najvyššou koncentráciou baktérií.
Portál Vigour Times podotýka, že použila Petriho misky, na ktoré dýchala a dotýkala sa ich rôznymi časťami svojho tela. Misky pritom nechala na teplom mieste niekoľko dní, aby umožnila baktériám rásť a až potom skontrolovala výsledky.
Tie boli, nielen pre ňu, ohromujúce. Najzamorenejšími baktériami totiž bol jej dych a prsty na rukách. Naproti tomu jej prsty na nohách, rebrá a nohy vykazovali výrazne menší rast baktérií.
Po zdieľaní svojich zistení na TikToku pritiahlo Chloeino video pozornosť používateľov tejto platformy, ktorú používajú najmä adolescenti. Bolo tomu aj vďaka jej komentáru: „Toľko rôznych kolónií!! Rebrá majú vždy najkrajšie baktérie.“
Niektorí sa vyjadrili k tomu, že nie všetky baktérie sú zlé, iných znepokojila vysoká koncentrácia baktérií vo vzorke jej dychu. Na druhej strane, iní žartom poznamenali, že po vzhliadnutí videa sa budú sprchovať desaťkrát.
Zaujímavosťou pritom je, že Chloe Fitzpatricková je dizajnérka, ktorá do svojich umeleckých diel baktérie často zahŕňa. Pre jej posledný projekt z roku 2022 „mikrobióm“ kultivovala baktérie z rastlín a rôznych častí svojho tela a uchovávala ich v živici na nosenie ako šperk. Priťahovali ju najmä žiarivé farby týchto mikroorganizmov, ako napríklad žltá a červená.
Podľa vedcov to je logické
Vedci tvrdia, že ústa človeka môžu obsahovať značné množstvo baktérií, plesní a vírusov, čo by vysvetľovalo, prečo Fitzpatrickovej dych vytvoril Petriho misku s najväčším množstvom baktérií.
Daily Mail uvádza, že ústa sú druhou najviac zamorenou oblasťou v tele, hneď po črevách, a obsahujú viac ako 20 miliárd baktérií. Hoci sa to môže zdať nechutné, podľa názoru vedcov, je úplne normálne mať tieto mikroorganizmy v ústach. Pomáhajú pri trávení a pomáhajú imunitnému systému naučiť sa rozdiel medzi bezpečnými a nebezpečnými baktériami.
Ale bez správnej ústnej hygieny môžu u niekoho viesť k zápachu z úst a taktiež problémom so zubami. Nedostatočné čistenie zubov umožňuje množenie baktérií v ústach, čo vedie k hromadeniu ďalších zlúčenín, ktoré môžu spôsobiť zápach z úst.
Doktorka Priya Deová, orálna mikrobiologička na Dental College and Hospital v indickom meste Puna, spolu s ďalšími odborníkmi už predtým v jednej štúdii napísali: „Ústa s rôznymi výklenkami sú mimoriadne komplexným prostredím, kde mikróby kolonizujú tvrdé povrchy zubov a mäkké tkanivá ústnej sliznice. Okrem toho, že je orálny mikrobióm iniciačným bodom trávenia, je rozhodujúci pri udržiavaní zdravia ústnej dutiny, ako aj celého tela.“
Nadviazala na predchádzajúci experiment
Jej experiment prichádza po tom, čo iný vedecký pracovník odhalil, že potriasť si ruky, aby ste ich vysušili, môže byť tou najhygienickejšou možnosťou. Aby zistil, či sušiče rúk pokrývajú vaše ruky baktériami, 33-ročný muž z Utahu držal Petriho misky pod strojmi.
Vzorkoval stroje na verejných toaletách, čerpacích staniciach, kinách a obchodoch naprieč svojho mesta Provo, asi 115-tisícové mesto v americkom štáte Utah. Po tom, čo Petriho misky nechal ležať tri dni, zistil že všetky riady boli plné baktérií a plesní, ktoré sa objavovali prostredníctvom bielych, žltých a čiernych škvŕn. Podľa jeho slov bol najkontaminovanejším sušič v kúpeľni. Tiež zistil, že Petriho miska mávajúca vzduchom, aby napodobňovala niekoho, ako si trasie ruky do sucha, zostala úplne čistá.
Čítajte viac z kategórie: Zahraničie
Zdroje: Head Topics, Vigour Times, Daily Mail










